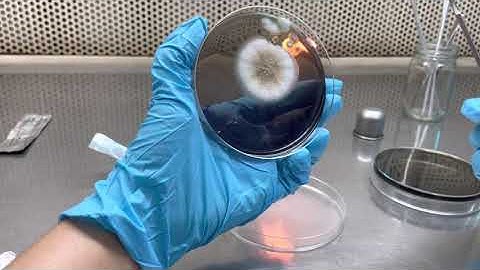
Fungi transfer on Agar (subculture)
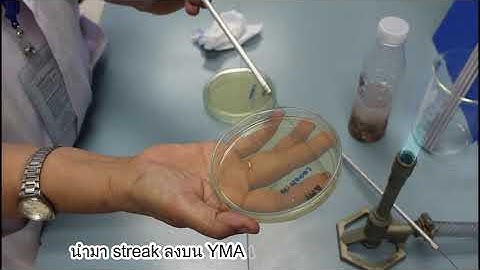
Mycology Lab Practical 2: Isolation of yeast from fermented food (parkia beans)

⬇ DOWNLOAD NOW
Kalau muncul iklan pop-up, tutup lalu klik tombol kembali
Download lagu Mycology Lab Practical 2: Single spore isolation secara gratis hanya untuk keperluan promosi. Dukung artis favorit kamu dengan membeli musik original di iTunes atau platform resmi lainnya.
 Mycology Lab Practical 2: Isolation of endophytic fungi
Mycology Lab Practical 2: Isolation of endophytic fungi
 Mycology Lab Practical 2: Isolation of mold from food samples
Mycology Lab Practical 2: Isolation of mold from food samples
 Single Spore/Monokaryotic Isolation Viewing for Clamp Connection Potential Monokaryon Isolate Part 1
Single Spore/Monokaryotic Isolation Viewing for Clamp Connection Potential Monokaryon Isolate Part 1
 Mycology Lab Practical 2: Transferring of Fungal Cultures
Mycology Lab Practical 2: Transferring of Fungal Cultures
 Isolating a single spore under the microscope
Isolating a single spore under the microscope
Fungi transfer on Agar (subculture)
Fungi transfer on Agar (subculture)
Mycology Lab Practical 2: Isolation of yeast from fermented food (parkia beans)
Mycology Lab Practical 2: Isolation of yeast from fermented food (parkia beans)
 Mycology Lab 101: Agar Work, Cloning, Spores & Sterile Culture Technique for Mushroom Cultivation
Mycology Lab 101: Agar Work, Cloning, Spores & Sterile Culture Technique for Mushroom Cultivation